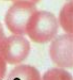
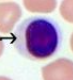

Tissues
Differentiating Tissues requires you to assess the following:
Cell Spacing
Cell Shape
Cell Layering
Epithelial:
Absorption
It makes up major tissue
On Free Surfaces
No Space
Protein
Readily Divides
Squamous
Fried Egg (Top/Side)

CubiItal
About as tall as it is wide

Columbar
Calumn-like
Taller than is wide

Simple Squamous
Air sacs of lungs
Walls of capillaries
The lining of blood/Lymph vessels

Simple Cubital
“Rings”
Surface of ovaries
Lining of kidneys
The lining of ducts of certain glands

Simple Columbar
Lining of Uterus
Lining of stomach
Lining of intestine

Psedostratisfied
The lining of respiratory passages
Chilia Swipe Away Stuff
Goblet cells release mucus

Stratified Squamous
Many layers of cells
Flattened towards the free surface of tissue
Dark at bottom
lighter at top
Protection
The outer layer of the Skin
The lining of the Oral Cavity
The lining of Throat, Vagina, and Anal Cavity

Stratified Cuboidal
The lining of large ducts of mammary glands
Sweat glands
Salivary Glands
Pancreas

Stratified Columbar
Vas Deferens
Parts of the male urethra
Parts of Plarynx

Transitional Epithelium
Distention
expansion on being filled with fluid, leading to an increase in volume
Inner Lining of the Urinary bladder and linings of part of the urethra
Are they flattening?
If not, then Transitional

Glands from the Exocrine System:
Merocrine
Most Common
Release Watery Fluids
Sweat
Saliva
Pancreatic Glands
Don’t lose any of themselves
Release out of themself
Apocrine
Will lose part of themselves
Take part of the cell body and break it off into the gland itself
external ear canal
Holocrine
Disintegrating cell
Use whole cell
Constantly dividing
Sebaceous glands
Produce Cbum
Hair on skin
Significance for Connective Tissue
3 main components to connective Tissue
Far more spread out
don’t use cells to identify it
Look in between
Extracellular matrix
Binding and Supporting
Protecting
Energy Fuel
Insulating
Strong reserve fuel
Transporting Substances within the body
Fibroblast
Produce Fibers
Black/Dark Purple Spots

Macrophages
clear foreign particles from tissues

Mast Cells
Release heparin and histamine

Collagen
You will see in tendons
White
Resists Pull
Thicker, but more transparent
Elastic Fibers
Thin black lines
Reticular
Thin Collagen Fibers
doesn’t have resistance to pull
Weak but can stretch and come back to normal shape
Loose Connective Tissue
Areolar
Binds organs together and holds tissue fluids in place
Location:
Beneath Skin
Between Muscles
Beneath Epithelial Tissue
Basement membrane (Connects)

Dense Connective Tissue
2 Types
Dense Regular
the fibers are layered in 1 direction
Dense Irregular
Fibers are all over the place
Collagen Fibers
Binding
Location
Tendons
Tough band of fibrous connective tissue
connects muscle to bone and is capable of withstanding tension
Function
to move our skeletal system, to move our bodies!
Ligaments
Fibrous tissue that connects bones to other bones.
AKA "articular ligaments", "fibrous ligaments", or "true ligaments"
They are found between bones
they hold the skeletal system together
Bone to Bone
Depper Skin Layers

Adipose Tissue
Look for bubbles and dark patches in between membranes
that’s the nuclei
IT IS NOT SIMPLE SQUAMOUS OR TRANSITIONAL

Cartilage
3 types
Hyaline Cartilage
Lacuna
Little Best Friend
Chondrocyte
Little Pocket
Matrix
Looks almost solid
Function
Supports
Protects
Provides framework
Location
Nose
Ends of Bones
Rings in the walls of respiratory passages



Elastic Cartilage
Sharp Cell Boundaries
In Lacuna
Little Pockets
More Visibal Fibers
See different coloring
Location
Larynx
The frame of External Ear
Function
Support
Flexible
Protects

Fibrocartilage
Has Cells in little pockets in a line
Parallel with each other
You can see dense fibers
Often times gets confused with dense regular
Function
Supports
Protects
Absorbs Shock
Location
Between Bony Parts of Spinal Column
Parts of the pelvic girdle

Sharp Cell Boundaries
Little pockets
Dense connective
Not a Fuzzy Edge, Clean Cut

Bone
Circles
Naturally an incredibly strong shape
Haversain System
Dots are cells (Osteocytes)
Has to be really strong
Has to be responsive
Dense MIneral Matrix
Connected by tubes
Runs blood through and nerves
“telescope into a larger one”
Function
Suports
Protects
Provides Framework
Location
Bones of Skeleton


Blood
Function
Transports substances
Helps maintain the stable internal environment
Location
Throughout the body within a closed system of blood vessels and heart chambers
Red Blood Cell
White Blood Cell
Lymphocyte
Neutrophil

Eosinophil

Plasma

Muscle Tissue
Skeletal
Striated
perpendicular lines
Voluntary
Big Cylinders
Glucose is stored in cells
Dark Disks
Cell Nuclei
More than one nucleus per cell
Function
Moves skeleton voluntarily
Location
Muscles attached to bones

Smooth
Lacks Striation
Involuntary
Looks Smeared
Funtion
Involentary movements if internal organs
Location
Walls of hollow internal organs

Cardiac
Striation
Involuntary
Cardiac Muscle Cell
Nuclei
Intercalated Discs
Funtion
Heart Movement
Location
Heart Muscle
Striated & Interclated Disks

Nervous Tissue
anything spreading out
Wires coming out of it
Function
Sensory Reception and conduction of nerve-impulsive
Location
Brain, Spinal Chord, Peripheral nerves
Can’t get more
How you learn
Alzheimers***